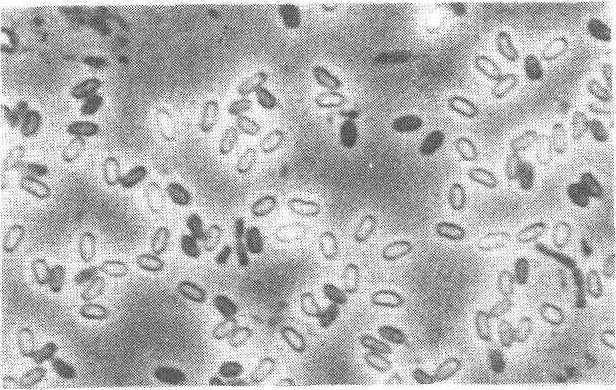

微粒子病pebrine disease
桑蚕的一种原虫病。由桑蚕微孢子虫经食下传染和胚种传染两种途径,侵染蚕体几乎所有组织而致病死亡。该病对养蚕生产危害极大,轻则降低养蚕收成,重则全部失收,严重威胁蚕种生产。世界各蚕区几乎都有发生。元代《农桑辑要》中已有类似此病的描述。日本群马县马场重久(1712年)《养蚕手鉴》中也有本病的记述。桑蚕微粒子病的首次流行,是1845年发生于法国沃克吕兹省(Vaucluse)主要蚕区,而后迅速传播蔓延到意大利、西班牙、叙利亚和罗马尼亚等国蚕区。1853~1865年,法国每年蚕茧产量因微粒子病危害损失5/6。当时,法、意等国不得不从日本进口大量蚕种,但日本也受到微粒子病的严重威胁。1865年,法国参议院收到了一份由3,500名养蚕业者联合签名的请愿书,要求解决微粒子病。于是法国农业部委托著名的微生物学家巴斯德(Louis Pasteur) 博士承担此项研究。经过5年工作,巴斯德确定了微粒子病是食下传染和胚种传染的一种蚕病,提出了袋蛾采种、检验母蛾、淘汰病卵以及消毒防病等一系列措施,从而控制了微粒子病的发生。其后,还有许多学者对微粒子病作了进一步研究。
病原 微粒子病的病原为桑蚕微孢子虫属微孢子虫科,微孢子虫属。学名为 Nosema bombycis Nageli。在细胞内寄生,只有孢子能在寄主体外生存。新鲜孢子呈椭圆形,长宽为3~4×1.5~2微米。孢子没有自身运动的能力。在显微镜下呈浅绿色,折光性强。孢子比重为1.30~1.35(图1)。孢子壳表面有微细缩皱,由蛋白质外被、几丁质厚层内壁以及形质膜3层组成。孢子内部含有极丝、极膜层、后极孢、两个核以及若干粗糙内质网膜等。孢子被桑蚕幼虫食下后,因消化液等的刺激作用,孢子放出极丝。极丝平均长度为124微米,是具有强贯穿力的细管,将芽体注入寄主细胞。刚放出的芽体具有一层形质膜、两个核、少量粗糙内质网膜以及特异的膜状物等。当侵入寄主细胞之后,保持着紧连的双核和多量的粗糙内质网膜。而后病原行分裂生殖,形成大量裂殖体。裂殖体细胞质的特征是具有内质网膜,核蛋白体、高尔基体等,但缺少线粒体。营养生殖期结束,孢子形成开始,裂殖体的细胞膜肥厚成孢子芽母细胞。孢子芽母细胞通常分裂成两个孢子芽,在其内部形成孢子小器官,最后成为孢子。微孢子虫的生活周期,最快需经4日,一般要经7~8日以上才能完成从孢子发芽到孢子形成一个生活周期(图2、图3)
图1 微粒子孢子
桑蚕体内几乎所有的组织,如消化管皮膜、中肠肌肉、血球、脂肪马氏管、气管、丝腺、生殖器官、体壁、神经系、背脉管等先后被微孢子虫寄生并形成病灶。中肠皮膜的病变引起消化功能的衰退,肌肉病灶的扩展导致病蚕行动滞呆,脂肪组织的崩溃造成血液混浊。绢丝腺的病变形成乳白脓疮病斑(图4),体壁真皮细胞的病变使体壁产生不规则的褐色病斑,生殖器官的感染成为经卵传染的源地。微孢子虫使蚕体内细胞质液化消耗,营养吸收和新陈代谢机能发生障碍,消化液和血液恶变,许多被寄生的细胞受到破坏,最后导致组织器官溃坏,蚕体死亡。

图2 微粒子孢子的结构
1. 极帽 2. 极膜层部
3. 极丝 4.孢子原生质
5. 外壳 6. 液孢
7. 核

图3 微粒子孢子虫发育圈
1. 中肠细胞内的孢子原生质
(芽体) 2~4.裂殖体
5~7. 胞子母细胞8. 成胞子
细胞 9. 未成熟孢
10. 成熟孢子 11. 成熟孢
子发芽

图4 微粒子病蚕绢丝腺病变
桑蚕微孢子虫孢子在室外太阳直射的干燥环境中,经30天后仍有0.4%的孢子生存。在明亮干燥条件下,经三个半月后孢子全部死亡。在明亮湿润条件下和在黑暗条件下以及在水中,经16个月后孢子才全部死亡。在土壤中经三个半月后孢子全部死亡。在下列各种消毒条件下,孢子全部失去活力:❶100℃蒸汽保持1小时;
❷100℃沸水15分钟:
❸1%有效氯的漂白粉液喷布并保持湿润状态30分钟:
❹含2%甲醛液每平方米喷洒225毫升,在24℃以上密闭一昼夜;
❺每立方米蚕室蒸熏3~4克毒消散,保持24℃密闭24小时。
传染 微粒子病传染途径有经口食下传染和经卵胚种传染两种。幼虫孵出时咬破卵壳或在以后各龄期食桑中食下微孢子虫孢子便会感染发病。一般在小蚕期或在同1龄的起蚕期最易感染发病。在整个蚕期中,凡是食用的桑叶接触到被病原孢子污染的贮桑室、桑篓、桑缸、桑刀、蚕室、蚕具以及饲养人员的手脚和养蚕用水等,均有可能传染致病。尤其是在中国南部蚕区,蚕室、桑田密集,1年中连续多次养蚕,蚕沙喂鱼,塘泥作桑肥,病原孢子污染程度较高,传染机会也较多。经卵传染系指上代幼虫食下少量病原孢子而仍能生育的病蛾产下患有微粒子病的蚕卵,这些病卵孵出来的幼虫,一般在各龄蚕期陆续病死,很少能结茧和传代。这些经卵传染的病蚕混杂于健康蚕群中饲养,还能引起蚕座内的重复感染。
桑蚕微粒子病的感受性强弱因蚕品种、自然环境、传染时期以及饲养条件而有差异。就蚕品种而言,欧洲系蚕品种较中国系蚕品种、日本系蚕品种容易感染;1化性蚕品种较2化性、多化性蚕品种容易感染;蚕期经过长、蚕体肥大以及丝量较多的蚕品种也易感染。自然环境条件同微粒子病的发生也有关系,高温干燥气候条件下发病较少,而低温多湿气候条件下则发病较多。以蚕种越年性而论,越年卵比不越年卵的微粒子病发生程度明显较高。在饲育方面,连续多次养蚕、蚕室布局不合理、微粒子病发生的机会也会增多。
桑蚕微粒子病的传染来源比较广泛,主要来源于病蚕、病蛹和病蛾尸体,例如一只病蛾体内就含有数以亿计的病原孢子;其次是病蚕的粪、尿、卵壳、蜕皮、蛹壳、鳞毛和茧壳等。此外,桑树害虫,如野桑蚕、桑毛虫、桑尺蠖、桑螟等;以及其他野外昆虫,如黄褐天幕毛虫、天蚕、柞蚕、樗蚕、甘蓝褐灯蛾、甘兰夜蛾等也可被桑蚕微孢子虫寄生。因此,必须注意防止通过这些昆虫的传染。
病征 桑蚕感染微粒子病后,在幼虫、蛹、蛾和卵各发育阶段均有不同的症状。经卵传染的蚁蚕,孵化后两日仍不疏毛,体色暗褐、蚕体瘦小,成长缓慢,发育不齐,出现较多的迟眠蚕或不眠蚕,一般在1~3龄期陆续死亡。4~5龄期病蚕的症状:眠期出现不眠蚕、迟眠蚕或蜕皮不良蚕,眠起后呈起缩病蚕而死;有些病蚕腹部体壁还发生不规则的黑褐色小病斑,熟蚕期的病蚕多数变成不结茧蚕而落地死亡。有的可勉强结成不整形茧或薄皮茧而逐渐死亡。病蛹的症状是体表无光泽,腹部松弛,反应迟钝,体壁上也有出现大小不一的黑褐色病斑。病蛾的症状,病重者羽化后不能穿茧而出,死在茧内;有些病蛾展翅不良或鳞毛脱落。病卵的症状为卵形不正,大小不一,产卵排列紊乱,卵粒容易脱落等。有些病卵在卵期陆续死亡。
诊断与防治 微粒子病肉眼鉴别的主要方法是检查5龄蚕的丝腺,如发现丝腺有乳白脓疮病斑,即可确认为微粒子病。其他一些病症是非特异性的,因而不能作为诊断微粒子病的依据。确诊微粒子病的方法是用600倍显微镜检验是否有病原孢子的存在。在检验病原孢子时,必须区别微粒子病孢子和其他类似孢子体(如花粉、真菌孢子等)。在镜检样品中,加入少量碘液,类似孢子的花粉粒便变成紫蓝色;如在样品中加入30%盐酸一滴,在27℃下放置10分钟,微孢子虫孢子可变形消失,而真菌孢子因其纤维素细胞壁抗酸的特性,形状不变。
防治微粒子病的方法是用显微镜进行母蛾检查,检出感染微粒子病的母蛾,并剔除微粒子病母蛾产下的蚕卵。除母蛾检验外,还须进行预知检查和补正检查(见微粒子病预知检查)。预知检查主要是对种茧用的原蚕,在整个蚕期对蚕卵、蚕体、蚕粪和蜕皮壳进行预知检验,预测微粒子病的感染程度。补正检查是对蚕种及其蚁蚕进行检验,核对母蛾检验的结果。如发现有漏检的病蛾和病卵,则应对号淘汰其病卵或病蚕。上述各种检验都是为了确保生产无微粒子病的蚕种,防止微粒子病的经卵传染。同时,在饲养原蚕的种场和原蚕区内要清除微粒子病传染源,严防孢子污染和扩散,彻底进行蚕室蚕具消毒和卵面消毒,防止微粒子病的食下传染。此外,在卵期和蛹期进行高温处理,对微粒子病有明显的治疗效果; 在化学药物治疗方面,苯来特和多菌灵对桑蚕微粒子病有一定的治疗效果。
微粒子病
由微粒子原虫引起的慢性蚕病,是蚕病学中具有遗传性的病类。蚕卵、幼虫、蛹、蛾都可发病。病蚕瘦小,发育缓慢,体呈“锈色”,常见起缩、斑点、半蜕皮或不蜕皮、不结茧或结薄皮茧等病状。著名微生物学家、化学家巴斯德于1870年建立了微粒子病原学说,并设计了单蛾制种法,为此病的预防奠定了基础。防治方法主要是:1.严格镜检,制造无毒蚕种。2.严格消、防毒,防止食下感染。